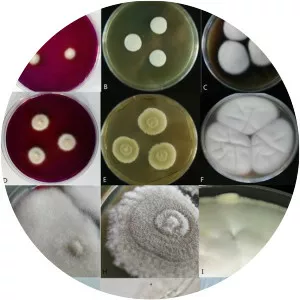
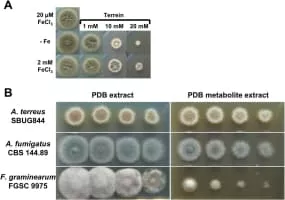

Aspergillus Terreus
| Use attributes for filter ! | |
| Scientific name | Aspergillus terreus |
|---|---|
| Rank | Species |
| Higher classification | Aspergillus |
| Family | Trichocomaceae |
| Kingdom | Fungi |
| Did you know | In humans, A. terreus is less commonly encountered as a pathogen than other species, most notably A. fumigatus, A. flavus and A. niger. |
| Date of Reg. | |
| Date of Upd. | |
| ID | 1177726 |
About Aspergillus Terreus
Aspergillus terreus, also known as Aspergillus terrestris, is a fungus found worldwide in soil. Although thought to be strictly asexual until recently, A. terreus is now known to be capable of sexual reproduction. This saprotrophic fungus is prevalent in warmer climates such as tropical and subtropical regions.